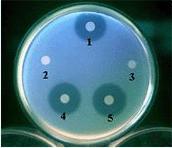
Bkb99.jpg

细菌素
| A+医学百科 >> 细菌素 |
细菌素(bacteriocin)
1.细菌产生的一种抗生代谢产物,对同源种或近似种才有拮抗作用;
2.蛋白质是主要成分;
3.有一定的作用机制(杀菌模式);
4.由质粒控制。
由细菌产生的有杀菌或抑菌作用的物质。主要含有具生物活性的蛋白质部分,对同种近缘菌株呈现狭窄的活性抑制谱,附着在敏感细胞特异性受点上。
细菌素的产生和寄主细胞对细菌素的免疫性都由质粒控制。细菌产生细菌素是细胞的致死过程。致死物质按其性质可分为两类,一类是低分子量的蛋白质或肽,很难在电子显微镜下观察到这类物质的结构,对胰蛋白酶多不稳定;另一类是具有复杂结构的蛋白质颗粒,有噬菌体部分形态结构,易于在电子显微镜下观察,对胰蛋白酶稳定。
1925年,A.格雷希亚首次报道了大肠杆菌V株产生一种对大肠杆菌Φ株有杀菌作用的物质,这类物质被称作大肠杆菌素。以后又发现许多细菌都能产生大肠杆菌素,而且产大肠杆菌素因子可以从供体细胞转移到受体细胞。
20世纪70年代以后,对细菌素的研究进入分子生物学水平,开展了对细菌素的化学性质、结构、生物合成、释放和作用方式等方面的探索。利用细菌素或与噬菌体方法结合,可以有效地进行某些细菌的分型和病原菌的流行检查。
参看
出自A+医学百科 “细菌素”条目 http://www.ye8.net/yixueshu/w/%E7%BB%86%E8%8F%8C%E7%B4%A0 转载请保留此链接
| 关于“细菌素”的留言: | |
|
目前暂无留言 | |
| 添加留言 | |